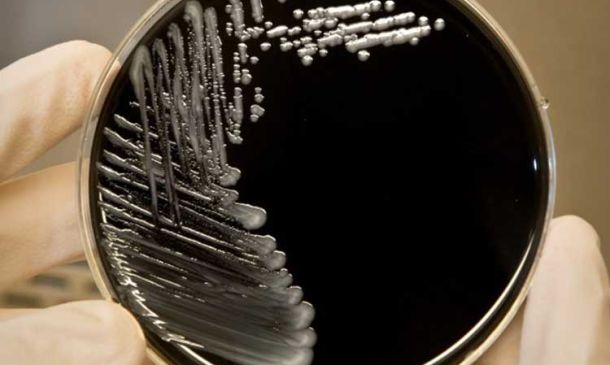

Le News selezionate da SITIP
Ultime News

Primo decesso dopo Fecal Microbiotia transplantation dovuta ad una acquisita infezione da ESBL.
21 Gennaio 2020
News Flash
Categorie News
News più lette
I vaccini antibatterici che prevengono l'antibiotico-resistenza.
30 Gennaio 2018
News dalla letteratura
Nuove linee guida per il trattamento della TB latente: raccomandazione dal National Tuberculosis Controllers Association e CDC, 2020.
09 Maggio 2020
News dalla letteratura
Vaccino pneumococcico coniugato 20 valente (PCV 20): prima approvazione pediatrica.
27 Settembre 2023
News SITIP
Stato dell’arte (01/04/21) dei vaccini anti-SARS-CoV-2 per l’età pediatrica.
06 Aprile 2021
News Covid